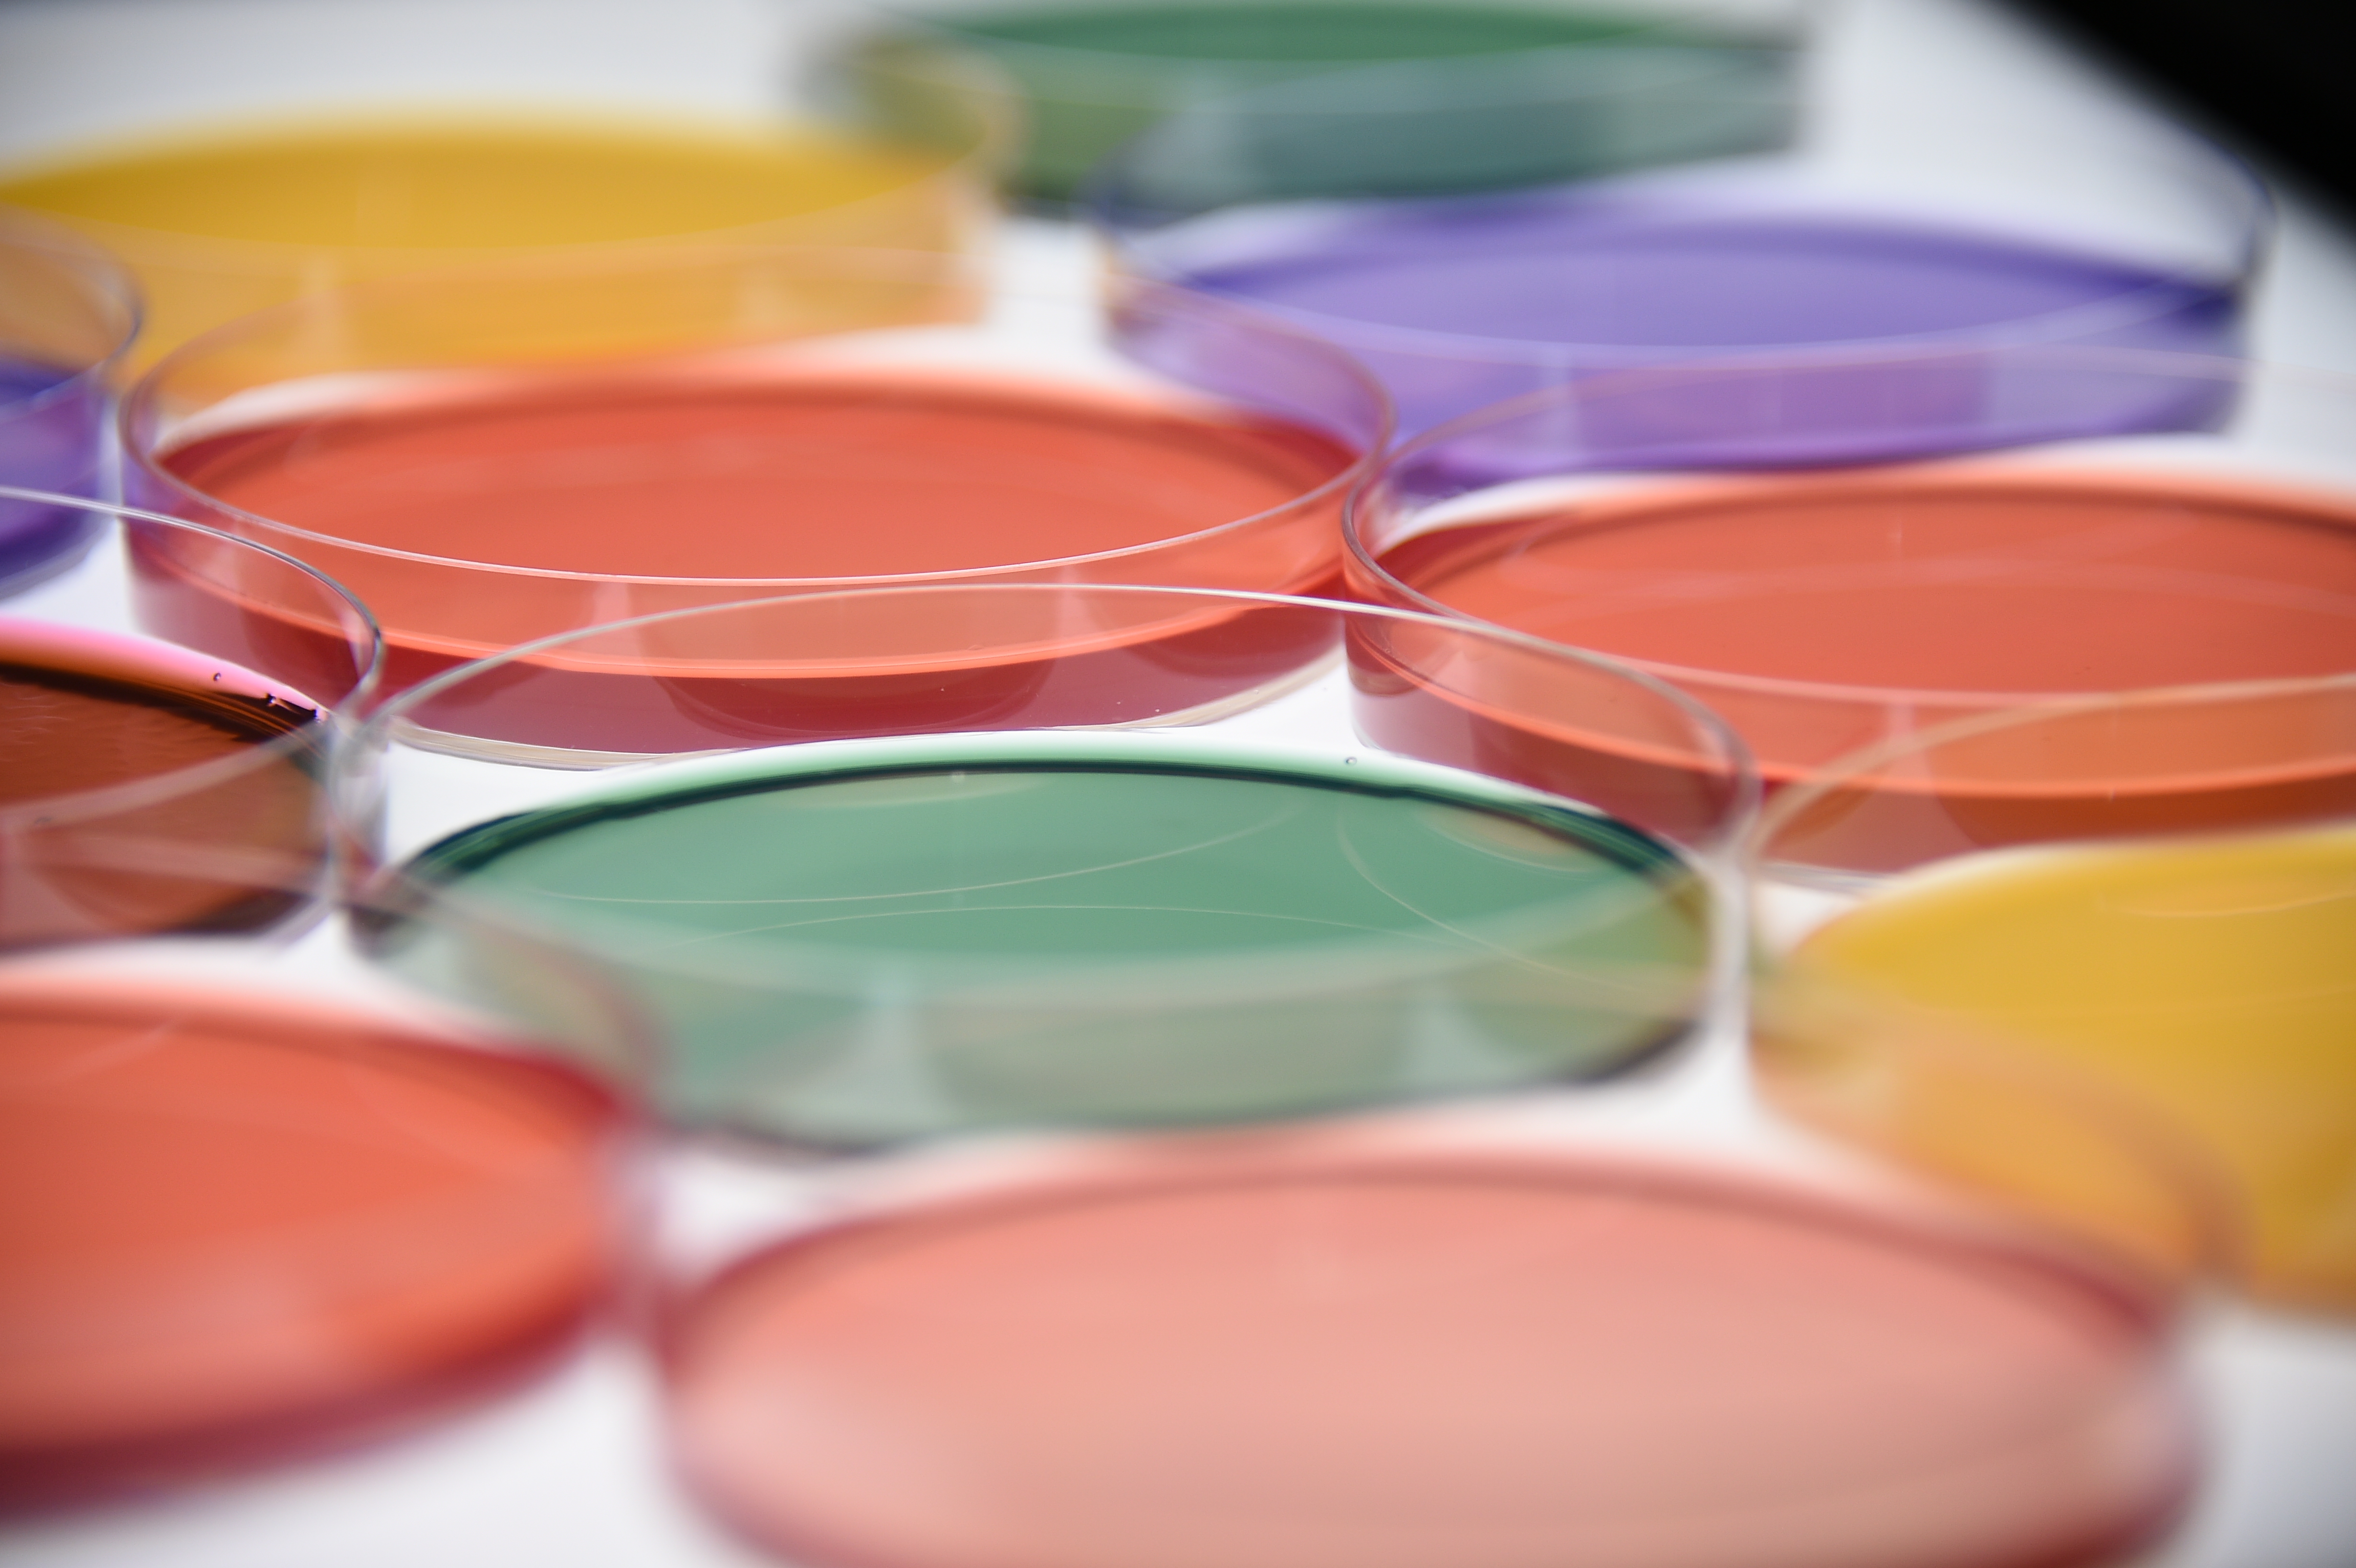
背景画像4
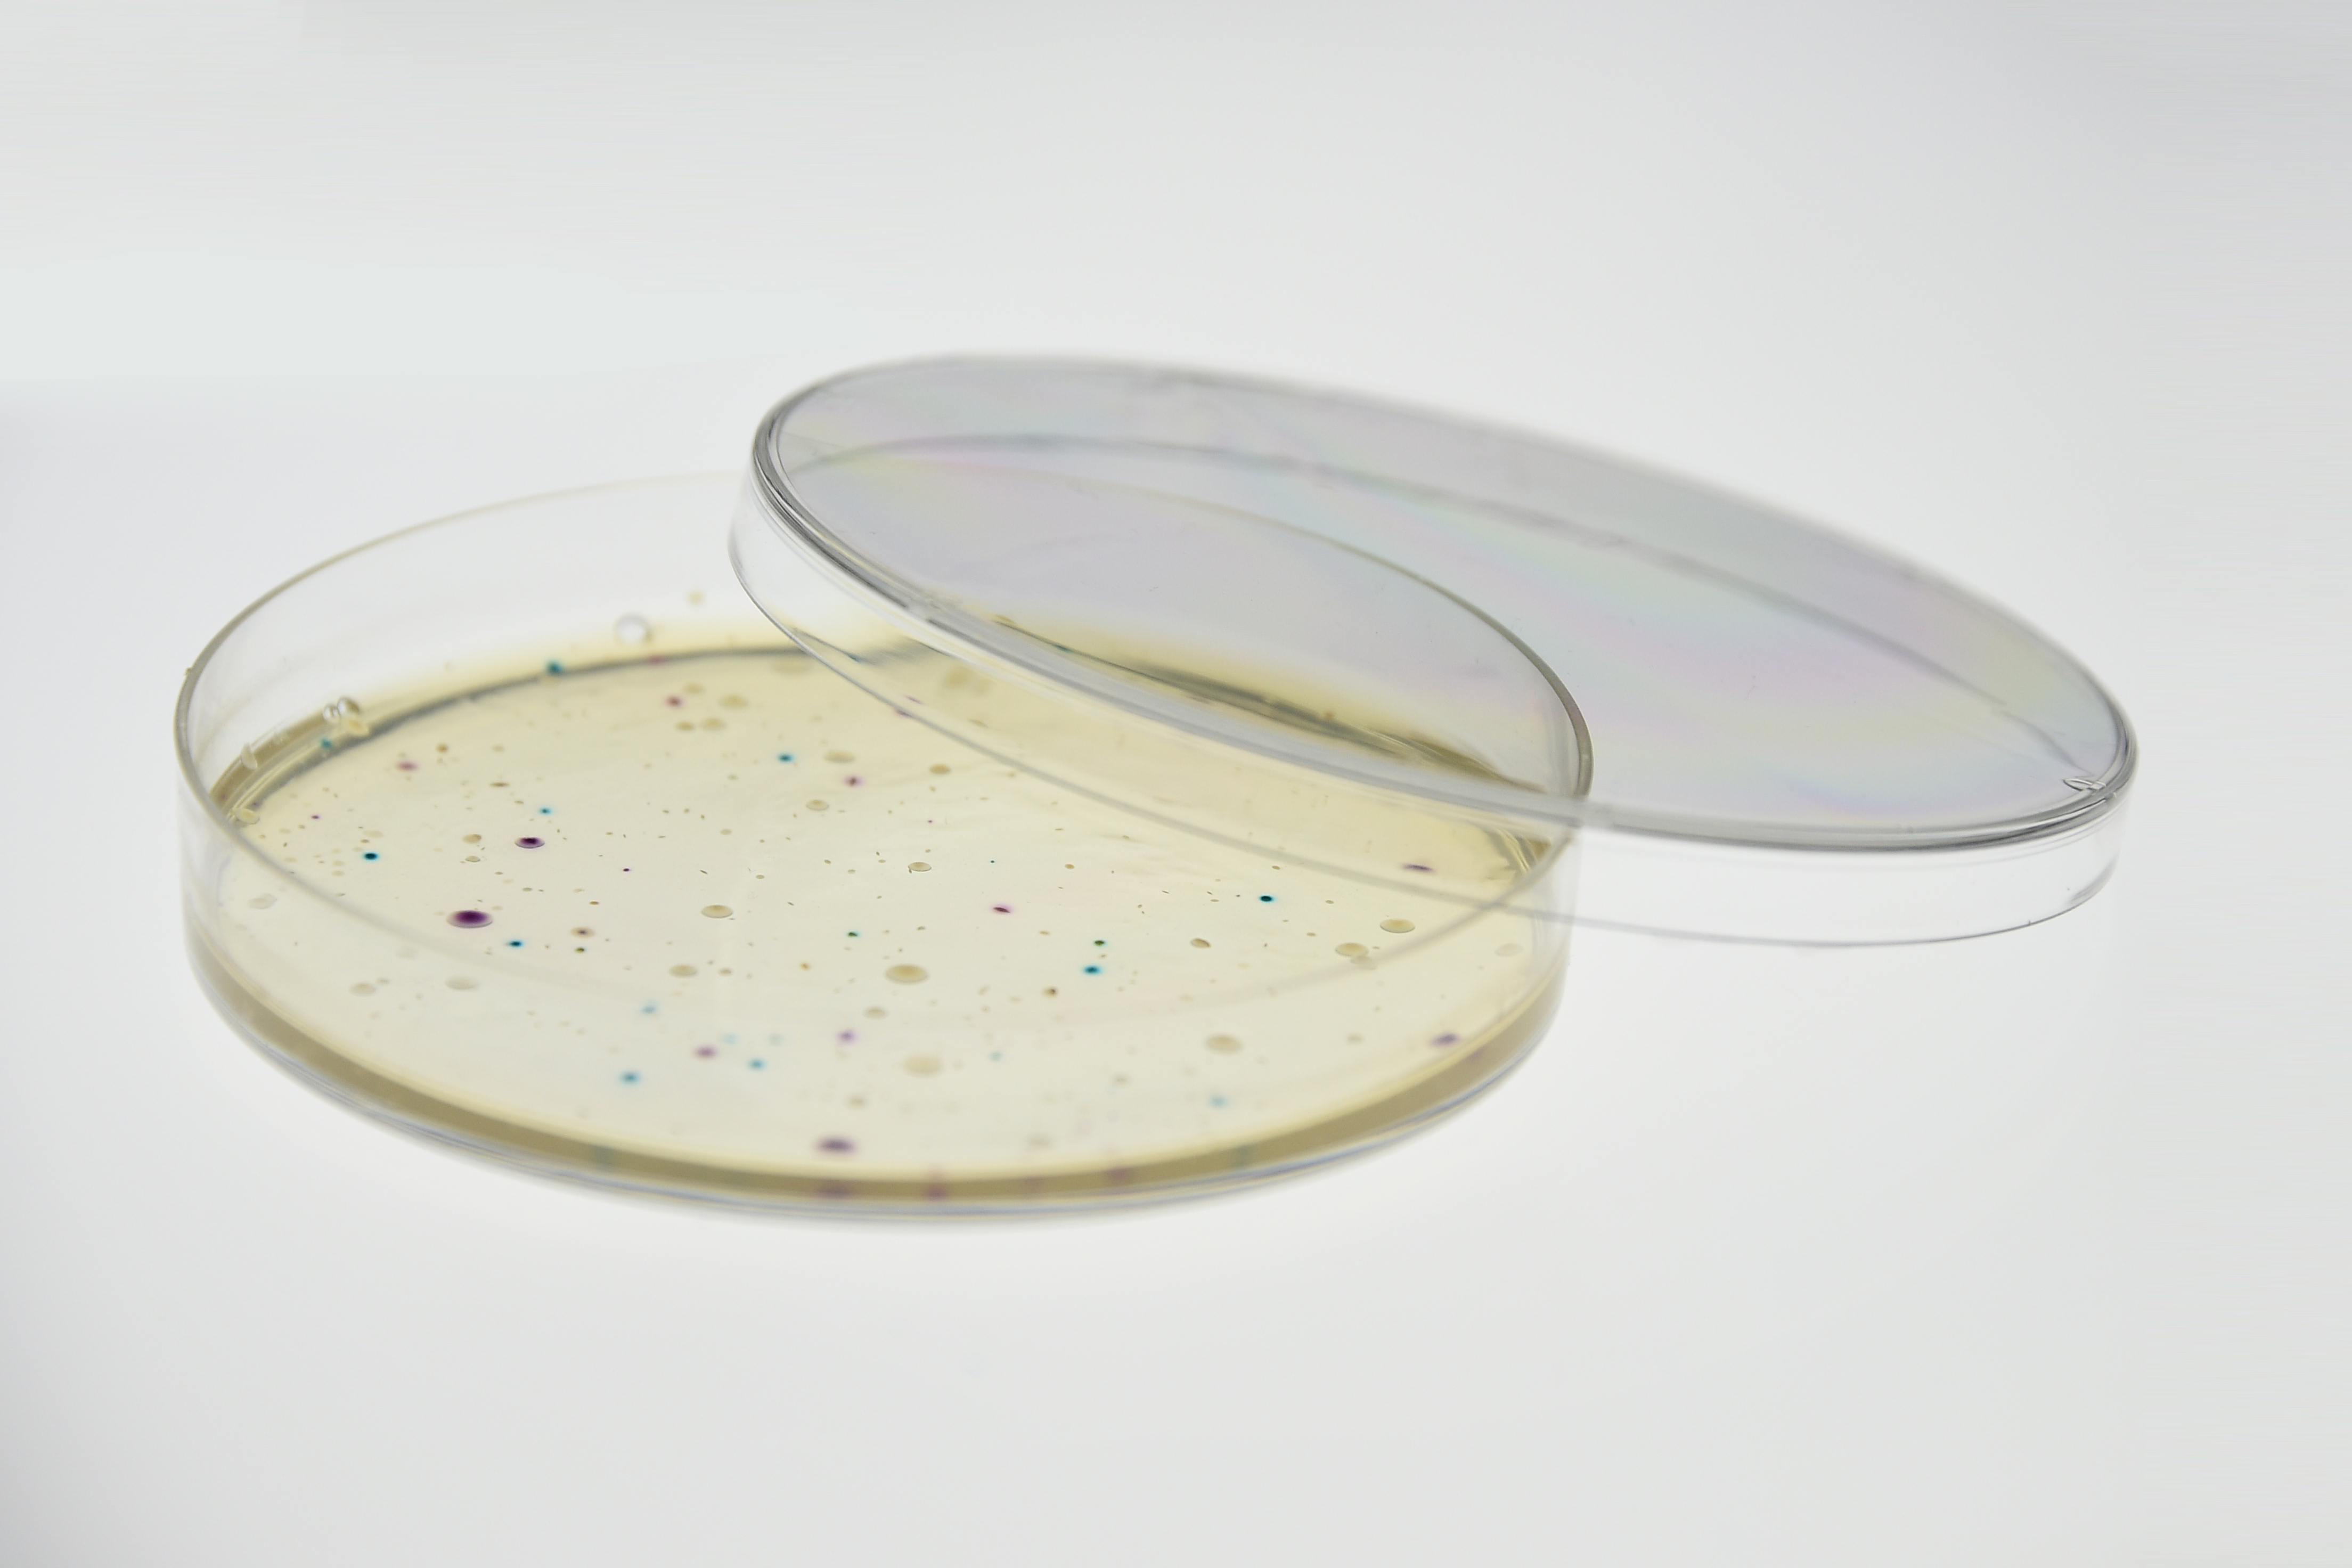
食品検査

News 新着情報
-
2024.10.22
味の違いを数値化! 味覚分析はじめました!!
弊社ではこの度、味覚分析の受託を開始致しました。
味の違いを機械で測定し、客観的な数値でご報告します。
詳細は【こちら】またはお問い合わせフォームよりお問合せ下さい。 -
2023.11.20
11月30日 第20回Q&C塾(Web版)開催‼
消費者の食の安全への関心の高まりから、認証取得に興味がある一方
どれを取得したら良いか分からない、自社には難しそう、と考える方も
多いのではと思います。本セミナーではHACCP第3者認証について、
Webにて、無料のセミナーを実施します。詳細は【こちら】をご覧ください。 -
2023.10.30
11月7日 Q&C塾ノロウイルス特別版(Web版)開催‼
ノロウイルスが心配な季節がやってきましたが、
みなさんの施設では対策はしっかりと出来ていますでしょうか。
ノロウイルス対策について、洗剤メーカーの方を講師にお呼びして、
Webにて、無料のセミナーを実施します。詳細は【こちら】をご覧ください。 -
2023.9.29
9月29日 第19回Q&C塾(Web版)開催‼
食品取扱施設においては食品安全は最重要課題ですが、
労働安全については皆さん取り組まれていますでしょうか。
食品安全と一緒に行う労働安全をテーマに労働安全の基本について、
Webにて、無料のセミナーを実施します。詳細は【こちら】をご覧ください。

©ISO17025認定機関 | AWラボアンドフーズ キュー・アンド・シー事業部
©ISO17025認定機関 | AWラボアンドフーズ キュー・アンド・シー事業部